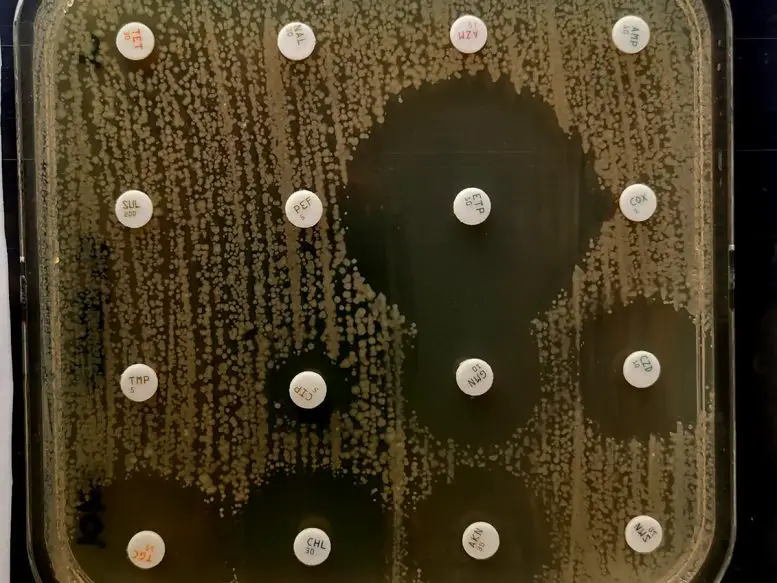

巴斯德研究所法国国家大肠杆菌、志贺氏菌和沙门氏菌参考中心的科学家检测到了广泛耐药(XDR)的志贺氏菌株的出现。志贺氏菌病是一种由志贺氏菌引起的高度传染性腹泻病,不仅在发展中国家流行,而且在法国这样的工业化国家也很流行,研究人员在那里已经监测了几年的传播。
对细菌基因组测序和病例特征的分析(大多数病例是在男性成年人中报告的)表明,这些最初来自南亚的菌株主要是在男男性行为者(MSM)中传播。
临床医生和实验室在检测MSM的性传播感染(STI)时需要考虑这一观察结果,如果分离出志贺氏菌株,应进行系统的抗生素分析,以改善对感染XDR菌株的病人的治疗。该结果发表在《自然-通讯》杂志上。
志贺氏菌病是一种高度传染性的腹泻疾病,通过粪便-口传播。在不同类型的志贺氏菌中,Shigella Sonnei(桑内志贺氏菌)是主要在工业化国家流通的物种。桑内志贺氏菌感染可引起短期腹泻(3-4天),可自行缓解。然而,对于中度至重度病例(血性腹泻、并发症风险)或在流行病情况下防止人与人之间的传播,抗生素治疗是必要的。因此,志贺氏菌获得的抗生素耐药机制限制了治疗方案。
在这项研究中,巴斯德研究所国家大肠杆菌、志贺氏菌和沙门氏菌参考中心(CNR-ESS)的科学家们证明了过去17年里在法国收集的桑内氏菌分离物中抗生素耐药性的增加。这项研究是基于对7000多个S. Sonnei分离物的分析,以及CNR-ESS在2005年至2021年间进行的全国志贺氏菌病监测中收集的流行病学信息。
CNR-ESS分析了其在法国各地的私营和公共合作实验室网络发送的所有细菌分离物。在这期间,被描述为"广泛耐药性"(XDR)的分离物在2015年首次被确认。科学家们随后观察到,对几乎所有推荐用于治疗志贺氏菌病的抗生素具有抗药性的XDR分离物的比例显著增加,并在2021年达到了一个高峰,当时所有索尼氏菌分离物(99例)中有22.3%是XDR。
基因组测序显示,所有这些法国的XDR菌株都属于同一个进化谱系,在2007年左右在南亚对一种关键的抗生素(环丙沙星)产生了抗性。在包括法国在内的世界几个地理区域,这些菌株随后获得了对其他一线抗生素(特别是第三代头孢菌素和阿奇霉素)的不同质粒编码的抗性。
对于严重的病例,唯一仍然有效的抗生素是碳青霉烯类药物或大肠杆菌素,它们必须静脉注射,导致更积极的治疗,需要在医院环境中进行更复杂的监测。
在法国,在各种情况下都观察到了XDR分离物:从南亚或东南亚返回的旅行者、2017年在一所学校爆发时(超过90例,导致学校关闭;索引病例从东南亚返回)以及男男性行为者(MSM)。后者被一种流行性克隆体感染,这种克隆体自2020年以来一直在整个欧洲蔓延,但在北美和澳大利亚也被发现。在MSM中循环的这个XDR菌株亚群是最广泛的,在2021年占法国XDR菌株的97%。
在南亚和东南亚,频繁使用抗生素,加上一些可能暴露于这种风险的人重复治疗性传播疾病,增加了选择XDR志贺菌株的可能性。需要进一步研究以了解不同的临床感染形式,特别是是否存在可能导致细菌更广泛传播的无症状形式。治疗试验对于确定治疗这些XDR志贺氏菌株的有效口服抗生素也至关重要。